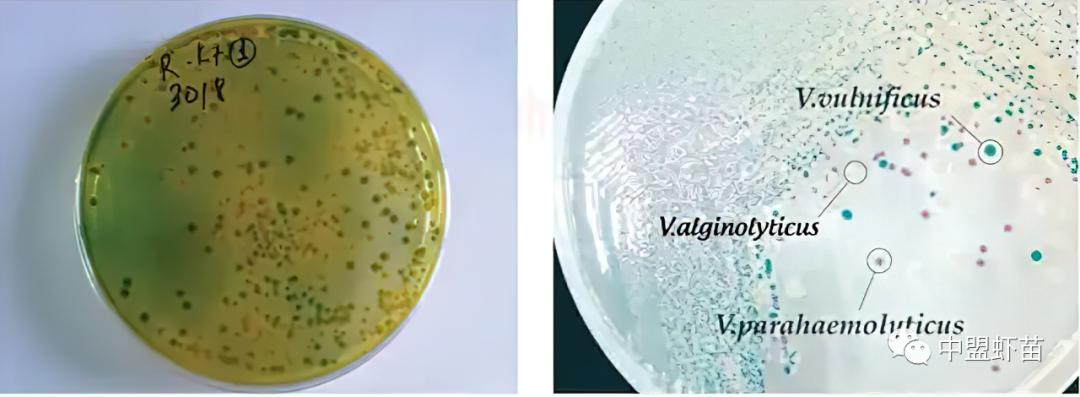
弧菌种类,弧菌大全

前言:
弧菌是引起对虾严重疾病的病原体之一。这些疾病可导致虾爆发高达100%的死亡率,对虾养殖业造成巨大损害,并极大地影响了过去十年越南,乃至整个亚洲对虾养殖的盈利能力。

一、什么是弧菌?
弧菌是革兰氏阴性菌的一个属,具有弯曲形状,其中几种可引起食物中毒,通常与食用未煮熟的海鲜有关。弧菌常见于海水环境中,是一种厌氧细菌,其检测呈阳性,且不形成孢子。
弧菌属,弧菌科,弧菌目,包括:γ-变形菌纲,变形菌门。弧菌的一般特征:革兰氏阴性,稍弯曲的形状,尺寸0.3-0.5x1.4-2.6μm。它们不形成孢子,并使用单个鞭毛或许多细长鞭毛移动。
它们都是兼性厌氧的,并且大部分在O/F葡萄糖培养基中氧化和发酵,琼脂TCBS是弧菌的选择性培养基,大多数物种生长在碱性海水中,刺激所有弧菌物种的生长,并且许多物种是绝对必需的;它们不在无盐(NaCl)环境中生长,不产生H2S。

霍乱弧菌
弧菌基本上,它们都生活在水生环境中,特别是海水和河口,也与海洋动物有关。有些物种是人类和海洋动物的病原体。与淡水中的气单胞菌类似,弧菌也存在于海水中。

弧菌菌落形态:(A) TCBS培养基上的霍乱弧菌菌落;(B) TCBS培养基上的副溶血弧菌菌落;(C) TCBS培养基上的创伤弧菌菌落;(D) TSAT培养基上的副溶血弧菌菌落。
在鱼类中,弧菌主要引起败血症。对于虾,弧菌属引起的疾病会发光,身体变红,并腐蚀甲壳质。引起水生动物疾病的物种有:副溶血弧菌、哈维弧菌、创伤弧菌……。

二、弧菌引起的疾病
几种弧菌已被确定为主要病原体,包括:副溶血弧菌和哈维弧菌,它们被描述为虾的主要病原体。哈维氏弧菌是一种发光病原体,可导致斑节对虾和南美白对虾的大规模死亡。
在甲壳、鳃部和肠道上发现了发光细菌,可在所有阶段引起疾病,但在虾苗阶段更常见。

患病发光的斑节对虾
早期死亡综合征或急性肝胰腺坏死病(EMS/AHPND)是由副溶血弧菌引起的疾病。副溶血弧菌是一种喜盐细菌,分布于全球温带和热带沿海水域,AHPND通常影响尚未达到商业尺寸(小于40天)的虾。

早期死亡综合征或急性肝胰腺坏死病(EMS/AHPND)
白便综合症也是与弧菌有关的疾病之一。松布恩等人(2012)报道了,在研究中从带有白便的南美白对虾中分离出的7种弧菌,包括:创伤弧菌、河流弧菌、副溶血弧菌、溶藻弧菌、发光弧菌、拟态弧菌和霍乱弧菌。
此外,某些菌株可引起人类急性胃肠炎,通常在食用受污染的海鲜后发生。
弧菌属,经常在咸水和淡水水生动物中引起疾病:比如:鱼类、甲壳类动物、软体动物……,当水生动物因不利的环境变化,而出现应激,甚至是感染其他疾病(如病毒、真菌、寄生虫)。
体弱的水生动物没有抵抗力,机会性弧菌菌种引起严重疾病,造成水生动物零星、大规模死亡,该病出现的季节取决于养殖物种和养殖地点。
根据一些研究表明,弧菌常见于海水和沿海水域、藻类培育池、丰年虫培育池和虾苗培育池中。育苗池内,弧菌数量随时间增加,底层高于表层,因此,底层排污有降低育苗池内弧菌密度的作用。
在海水网箱养殖的鱼类中,这种疾病的病理症状类似于由运动性气单胞菌引起的败血症。

三、虾类和其他水生物种感染弧菌后的病理症状
当虾或其他水生物种感染弧菌时,会出现以下症状:
1、 虾处于异常状态:浮到池塘表面,漂到岸边,成群结队地游来游去。
2、 虾、蟹精神不振、食欲不佳或甚至不进食。
3、 虾有红色或蓝色的颜色变化。虾、蟹的壳质软、外壳及在壳和附属部位上有腐蚀伤。
4、 虾苗在感染副溶血弧菌和哈维伊弧菌时会发光。
5、 当甲壳类虾苗感染溶藻弧菌时,触角、头胸部、身体和附肢会出现红色斑点。
6、 感染弧菌属的鲍鱼幼苗,会从粉红色变为红色。
7、 感染弧菌的螃蟹在血液中24-48小时后,会出现由血细胞和细菌组成的凝集(沉淀)。
8、 在网箱养殖的鱼类中,这种疾病具有与气单胞菌引起的类似败血症的病理症状。

感染弧菌的斑节对虾:

感染弧菌属细菌的鱼类:

四、如何控制弧菌引起的疾病
1、预防弧菌引起的疾病
保持弧菌浓度低于最大阈值:
池塘水中的总弧菌:103-104 CFU/mL;
虾肠内弧菌总数:105 CFU/g
其中:
绿色菌落:102 CFU/mL;
黄色菌落:103 CFU/mL
2、除了使用 SPF(不含特定病原体)虾苗。养殖场需采取以下措施:
①水源通过过滤,并用紫外线进行处理。
②用20-25ppm福尔马林处理亲虾30-60分钟;
③用10-15ppm二氯在淡水中处理卤虫1小时,在孵化前取出并清洗。
④可*池猫**使用EDTA 2-5ppm,以抑制细菌生长。
⑤定期对底部进行吸污,以减少育苗池底部的细菌数量。
⑥使用生物制品对抗致病性弧菌和机会性细菌。益生菌通过直接吸收或分解水中的有机物来维持良好的水质。常用于此目的的一些菌株包括:亚硝化单胞菌属、硝化杆菌、亚硝化球菌、芽孢杆菌。
此外,益生菌还被用作预防和治疗措施,通过营养来增强动物健康。此外,使用益生菌、益生元、合生元、生物絮凝剂,也可以起到预防和控制弧菌爆发的作用。
益生菌可通过与弧菌竞争营养和空间或产生抑制细菌生长的物质的机制,来消除系统中的致病性、机会性弧菌。
简而言之,要管理弧菌,必须重点关注水体中的有机物。